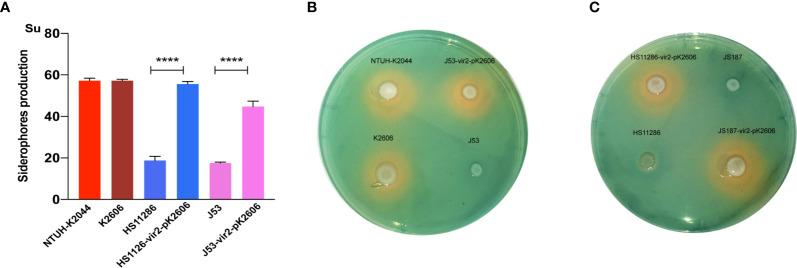
https://cdn.ncbi.nlm.nih.gov/pmc/blobs/b233/8485780/e8ea3e9f339e/fcimb-11-752011-g003.jpg

从 CG23 超强毒力株获得的结合毒性质粒增强了细菌的毒力。
Acquisition of the Conjugative Virulence Plasmid From a CG23 Hypervirulent Strain Enhances Bacterial Virulence.
机构信息
Department of Clinical Laboratory, Huashan Hospital of Fudan University, Shanghai, China.
Department of Clinical Laboratory, The First Affiliated Hospital of Guangxi Medical University, Nanning, Guangxi, China.
出版信息
Front Cell Infect Microbiol. 2021 Sep 9;11:752011. doi: 10.3389/fcimb.2021.752011. eCollection 2021.
The emergence of hypervirulent and carbapenem-resistant (hv-CRKP) has become a hot topic and confounding problem for clinicians and researchers alike. Conjugative virulence plasmids have the potential to cause more threatening dissemination of hv-CRKP strains. We previously identified K2606, a CG23 clinical hypervirulent strain of harboring a conjugative virulence plasmid designated pK2606. In this study we examined hypervirulence levels using assays of biofilm formation, serum resistance, and wax larvae and mouse infection models. Moreover, to define the transfer ability of pK2606 and whether this confers hypervirulence to other strains we performed plasmid transconjugation experiments between K2606 and the ST11 CRKP strain HS11286 along with J53. We found that although biofilm formation and serum resistance were not significantly increased, the transconjugants acquired the ability of produce high level of siderophores and also caused high mortality of wax larvae and mice. Furthermore, we identified pK2606-like conjugative virulence plasmids in GenBank, providing evidence that such plasmids may have begun to spread throughout China. These findings provide an evidence base for the possible mechanisms of the emergence of hv-CRKP strains and highlight the potential of pK2606-like conjugative virulence plasmids to spread worldwide.
产超广谱β-内酰胺酶和碳青霉烯类耐药的(hv-CRKP)的出现已经成为临床医生和研究人员共同关注的热点和难题。可移动的毒力质粒有可能导致 hv-CRKP 菌株更具威胁性的传播。我们之前已经鉴定出 K2606,它是一个 CG23 临床超毒力的携带一个命名为 pK2606 的可移动毒力质粒的菌株。在这项研究中,我们使用生物膜形成、血清抗性和蜡幼虫以及小鼠感染模型来检测超毒力水平。此外,为了确定 pK2606 的转移能力以及它是否赋予其他菌株超毒力,我们在 K2606 和 ST11 CRKP 菌株 HS11286 以及 J53 之间进行了质粒转导实验。我们发现,尽管生物膜形成和血清抗性没有显著增加,但转导子获得了产生高水平铁载体的能力,也导致了蜡幼虫和小鼠的高死亡率。此外,我们在 GenBank 中鉴定出了 pK2606 样可移动毒力质粒,这为这种质粒可能已经开始在中国传播提供了证据。这些发现为 hv-CRKP 菌株出现的可能机制提供了证据,并强调了 pK2606 样可移动毒力质粒在全球传播的潜力。